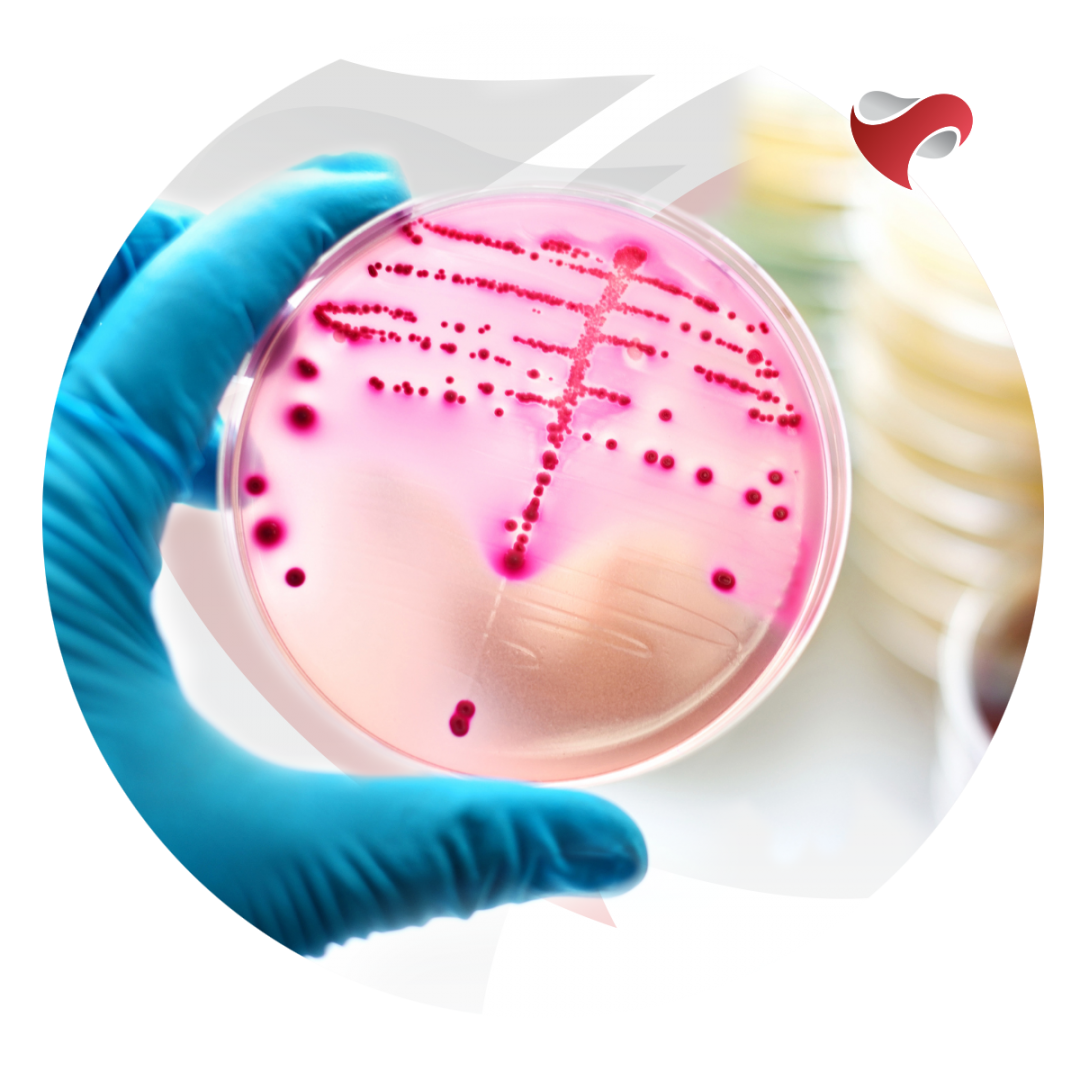

Uma Possível Cura para Aids?
 Em um grande esforço colaborativo, pesquisadores da Escola de Medicina da Universidade de Temple e do Centro Médico da Universidade de Nebraska (UNMC), eliminaram pela primeira vez o DNA do HIV-1 competente para replicação (o vírus responsável pela AIDS) de os genomas de animais vivos.
Em um grande esforço colaborativo, pesquisadores da Escola de Medicina da Universidade de Temple e do Centro Médico da Universidade de Nebraska (UNMC), eliminaram pela primeira vez o DNA do HIV-1 competente para replicação (o vírus responsável pela AIDS) de os genomas de animais vivos.
O estudo, publicado on-line em 2 de julho na revista Nature Communications, marca um passo crítico em direção ao desenvolvimento de uma possível cura para a infecção humana pelo HIV.
"Nosso estudo mostra que o tratamento para suprimir a replicação do HIV e a terapia de edição de genes, quando administrados seqüencialmente, podem eliminar o HIV de células e órgãos de animais infectados", disse Kamel Khalili, PhD, Laura H. Carnell e presidente do Departamento de Neurociência.
O tratamento atual para o HIV concentra-se no uso de terapia anti-retroviral (TARV). O TARV suprime a replicação do HIV, mas não elimina o vírus do corpo. Portanto, o TARV não é uma cura para o HIV, e requer uso por toda a vida. Se for interrompido, o HIV se recupera, renovando a replicação e alimentando o desenvolvimento da AIDS.
A repercussão do HIV é diretamente atribuída à capacidade do vírus de integrar sua sequência de DNA nos genomas das células do sistema imunológico, onde ele fica inativo e fora do alcance dos medicamentos anti-retrovirais.
Em trabalhos anteriores, a equipe do Dr. Khalili usou a tecnologia CRISPR-Cas9 para desenvolver um novo sistema de edição genética e de terapia gênica que visa remover o DNA do HIV dos genomas que abrigam o vírus.
Em ratos e camundongos, eles mostraram que o sistema de edição de genes poderia efetivamente extirpar grandes fragmentos de DNA de HIV de células infectadas, impactando significativamente a expressão gênica viral.
Para o novo estudo, Dr. Khalili e seus colegas combinaram seu sistema de edição genética com uma estratégia terapêutica desenvolvida recentemente conhecida como ART de liberação lenta de longa duração (LASER).
O LASER ART tem como alvo os santuários virais, mantendo a replicação do HIV em níveis baixos por longos períodos de tempo, reduzindo a frequência de administração de TAR. Os medicamentos de longa duração foram possíveis graças às alterações farmacológicas na estrutura química dos medicamentos anti-retrovirais.
Segundo o Dr. Khalili, "Queríamos ver se o LASER ART poderia suprimir a replicação do HIV por tempo suficiente para que o CRISPR-Cas9 eliminasse totalmente as células do DNA viral".
Para testar sua ideia, os pesquisadores usaram camundongos manipulados para produzir células T humanas suscetíveis à infecção pelo HIV, permitindo a infecção viral a longo prazo e a latência induzida pela terapia antirretroviral. Uma vez estabelecida a infecção, os ratos foram tratados com LASER ART e subsequentemente com CRISPR-Cas9. No final do período de tratamento, os ratos foram examinados quanto à carga viral. As análises revelaram a eliminação completa do DNA do HIV em cerca de um terço dos ratos infectados pelo HIV.
"A grande mensagem deste trabalho é que é preciso tanto o CRISPR-Cas9 quanto a supressão de vírus por meio de um método como o LASER ART, administrado em conjunto, para produzir uma cura para a infecção pelo HIV", disse Khalili. "Agora temos um caminho claro para avançar para testes em primatas não humanos e possivelmente ensaios clínicos em pacientes humanos durante o ano."
O estudo apresenta muito potencial para a cura do HIV.
Para mais informações converse com o seu médico.
Fonte:ScienceDaily.